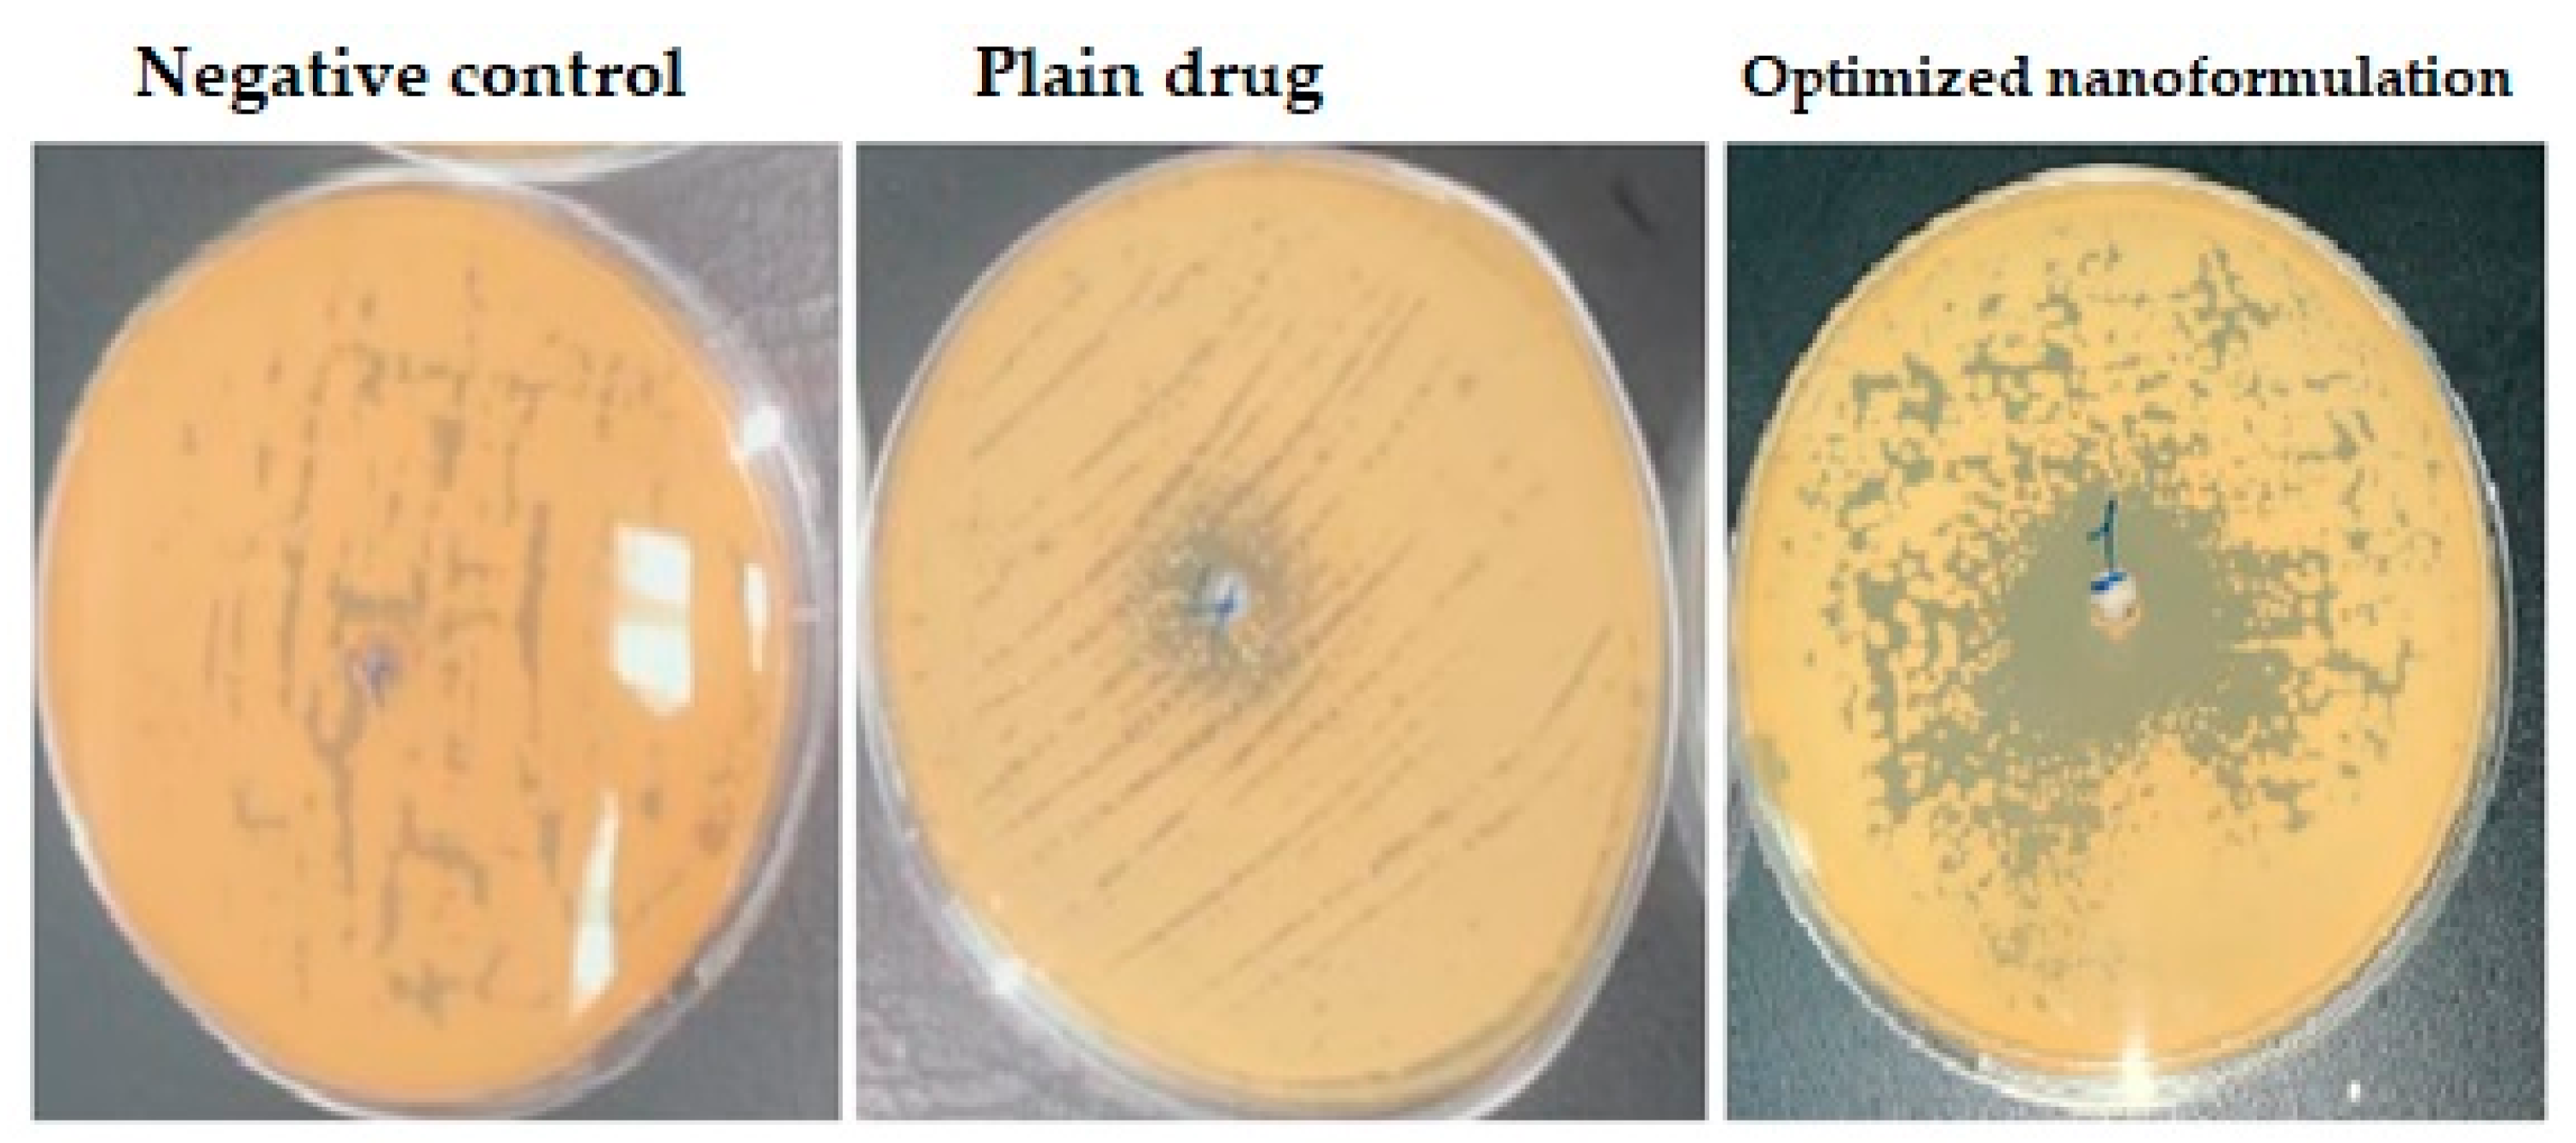
Polymers 15 00209 g006 Polymers 15 00209 g006

Enhancing the Antifungal Activity and Ophthalmic Transport of Fluconazole from PEGylated Polycaprolactone Loaded Nanoparticles
Abstract
1. Introduction
2. Materials and Methods
2.1. Materials
2.2. Design of Experiment
2.3. Preparation of FLZ Nanoparticles
2.4. Characterization of the Prepared Polymeric Nanoparticles Formulations
2.4.1. Particle Size, Polydispersity Index and Zeta Potential Measurements
2.4.2. Entrapment Efficiency (EE) Measurement
2.5. Box-Behnken Design Statistical Analysis
2.6. Morphological Study
2.7. In-Vitro Antifungal Susceptibility Testing
2.8. Preparation of Ophthalmic Formulations
2.9. Rheological Behaviour
2.10. In Vitro Drug Release
2.11. Rabbit Eye Irritation Test
2.12. Ocular Transport Study
3. Results and Discussion
3.1. Development of FLZ-Loaded Nanoparticles
3.2. Optimization of the Polymeric Nanoparticles
3.388 X2X2 − 0.037 X2X3 − 0.0004 X3X3
0.069 X2X2 − 0.0012 X2X3 + 0.0001 X3X3
0.0004 X1X3 + 0.001 X2X2 + 0.0005 X2X3 + 0.0000002 X3X3
3.2.1. Impact of the Studied Factors on the Particle Size (Y1)
3.2.2. Impact of the Studied Factors on the Zeta Potential (Y2)
3.2.3. Impact of the Studied Factors on the EE % (Y3)
3.2.4. Validation of the Optimized FLZ-Loaded Nanoparticles
3.3. Morphological Study of the Optimized Polymeric Nanoparticles
3.4. In Vitro Antifungal Susceptibility Testing
3.5. Rheological Behaviour of the Prepared Ophthalmic Formulations
3.6. In Vitro Release Study and Kinetic Treatment of the Data
3.7. Rabbit Eye Irritation Test
3.8. Ocular Transport Study
4. Conclusions
Author Contributions
Funding
Institutional Review Board Statement
Informed Consent Statement
Data Availability Statement
Acknowledgments
Conflicts of Interest
References
- Löscher, M.; Seiz, C.; Hurst, J.; Schnichels, S. Topical Drug Delivery to the Posterior Segment of the Eye. Pharmaceutics 2022, 14, 134. [Google Scholar] [CrossRef] [PubMed]
- Varela-Fernández, R.; Díaz-Tomé, V.; Luaces-Rodríguez, A.; Conde-Penedo, A.; García-Otero, X.; Luzardo-Álvarez, A.; Fernández-Ferreiro, A.; Otero-Espinar, F.J. Drug Delivery to the Posterior Segment of the Eye: Biopharmaceutic and Pharmacokinetic Considerations. Pharmaceutics 2020, 12, 269. [Google Scholar] [CrossRef]
- Gote, V.; Sikder, S.; Sicotte, J.; Pal, D. Ocular drug delivery: Present innovations and future challenges. J. Pharmacol. Exp. Ther. 2019, 370, 602–624. [Google Scholar] [CrossRef]
- Begines, B.; Ortiz, T.; Pérez-Aranda, M.; Martínez, G.; Merinero, M.; Argüelles-Arias, F.; Alcudia, A. Polymeric nanoparticles for drug delivery: Recent developments and future prospects. Nanomaterials 2020, 10, 1403. [Google Scholar] [CrossRef] [PubMed]
- Ludwig, A. The use of mucoadhesive polymers in ocular drug delivery. Adv. Drug Deliv. Rev. 2005, 57, 1595–1639. [Google Scholar] [CrossRef] [PubMed]
- Varshochian, R.; Riazi-Esfahani, M.; Jeddi-Tehrani, M.; Mahmoudi, A.R.; Aghazadeh, S.; Mahbod, M.; Movassat, M.; Atyabi, F.; Sabzevari, A.; Dinarvand, R. Albuminated PLGA nanoparticles containing bevacizumab intended for ocular neovascularization treatment. J. Biomed. Mater. Res.-Part A 2015, 103, 3148–3156. [Google Scholar] [CrossRef]
- Ryu, W.M.; Kim, S.N.; Min, C.H.; Choy, Y. Bin Dry tablet formulation of plga nanoparticles with a preocular applicator for topical drug delivery to the eye. Pharmaceutics 2019, 11, 651. [Google Scholar] [CrossRef]
- Boia, R.; Dias, P.A.N.; Martins, J.M.; Galindo-Romero, C.; Aires, I.D.; Vidal-Sanz, M.; Agudo-Barriuso, M.; de Sousa, H.C.; Ambrósio, A.F.; Braga, M.E.M.; et al. Porous poly(ε-caprolactone) implants: A novel strategy for efficient intraocular drug delivery. J. Control. Release 2019, 316, 331–348. [Google Scholar] [CrossRef]
- Lynch, C.; Kondiah, P.P.D.; Choonara, Y.E.; du Toit, L.C.; Ally, N.; Pillay, V. Advances in biodegradable nano-sized polymer-based ocular drug delivery. Polymers 2019, 11, 1371. [Google Scholar] [CrossRef]
- Raj, N.; Vanathi, M.; Ahmed, N.H.; Gupta, N.; Lomi, N.; Tandon, R. Recent perspectives in the management of fungal keratitis. J. Fungi 2021, 7, 907. [Google Scholar] [CrossRef]
- Bellamine, A.; Lepesheva, G.I.; Waterman, M.R. Fluconazole binding and sterol demethylation in three CYP51 isoforms indicate differences in active site topology. J. Lipid Res. 2004, 45, 2000–2007. [Google Scholar] [CrossRef] [PubMed]
- Charoo, N.; Cristofoletti, R.; Graham, A.; Lartey, P.; Abrahamsson, B.; Groot, D.W.; Kopp, S.; Langguth, P.; Polli, J.; Shah, V.P.; et al. Biowaiver monograph for immediate-release solid oral dosage forms: Fluconazole. J. Pharm. Sci. 2014, 103, 3843–3858. [Google Scholar] [CrossRef] [PubMed]
- Charoo, N.A.; Cristofoletti, R.; Dressman, J.B. Risk assessment for extending the Biopharmaceutics Classification System-based biowaiver of immediate release dosage forms of fluconazole in adults to the paediatric population. J. Pharm. Pharmacol. 2015, 67, 1156–1169. [Google Scholar] [CrossRef] [PubMed]
- Tverdek, F.P.; Kofteridis, D.; Kontoyiannis, D.P. Antifungal agents and liver toxicity: A complex interaction. Expert Rev. Anti. Infect. Ther. 2016, 14, 765–776. [Google Scholar] [CrossRef] [PubMed]
- Yu, D.T.; Peterson, J.F.; Seger, D.L.; Gerth, W.C.; Bates, D.W. Frequency of potential azole drug-drug interactions and consequences of potential fluconazole drug interactions. Pharmacoepidemiol. Drug Saf. 2005, 14, 755–767. [Google Scholar] [CrossRef]
- Fernandes, A.V.; Pydi, C.R.; Verma, R.; Jose, J.; Kumar, L. Design, preparation and in vitro characterizations of fluconazole loaded nanostructured lipid carriers. Braz. J. Pharm. Sci. 2020, 56, 18069. [Google Scholar] [CrossRef]
- Habib, F.S.; Fouad, E.A.; Abdel-Rhaman, M.S.; Fathalla, D. Liposomes as an ocular delivery system of fluconazole: In-vitro studies. Acta Ophthalmol. 2010, 88, 901–904. [Google Scholar] [CrossRef]
- Rençber, S.; Karavana, S.Y.; Yılmaz, F.F.; Eraç, B.; Nenni, M.; Özbal, S.; Pekçetin, Ç.; Gurer-Orhan, H.; Hoşgör-Limoncu, M.; Güneri, P.; et al. Development, characterization, and in vivo assessment of mucoadhesive nanoparticles containing fluconazole for the local treatment of oral candidiasis. Int. J. Nanomed. 2016, 11, 2641–2653. [Google Scholar] [CrossRef]
- Silva, G.R.; Almeida, A.P.R.; Fernandes-Cunha, G.M.; Castro, B.F.M.; Vieira, L.C.; Fulgêncio, G.O.; Silva-Cunha, A.; Fialho, S.L. Safety and in vivo release of fluconazole-loaded implants in rabbits’ eyes. J. Drug Deliv. Sci. Technol. 2016, 35, 323–326. [Google Scholar] [CrossRef]
- Winkler, J.S.; Barai, M.; Tomassone, M.S. Dual drug-loaded biodegradable Janus particles for simultaneous co-delivery of hydrophobic and hydrophilic compounds. Exp. Biol. Med. 2019, 244, 1162–1177. [Google Scholar] [CrossRef]
- Badri, W.; Miladi, K.; Nazari, Q.A.; Fessi, H.; Elaissari, A. Effect of process and formulation parameters on polycaprolactone nanoparticles prepared by solvent displacement. Colloids Surfaces A Physicochem. Eng. Asp. 2017, 516, 238–244. [Google Scholar] [CrossRef]
- El-Housiny, S.; Eldeen, M.A.S.; El-Attar, Y.A.; Salem, H.A.; Attia, D.; Bendas, E.R.; El-Nabarawi, M.A. Fluconazole-loaded solid lipid nanoparticles topical gel for treatment of pityriasis versicolor: Formulation and clinical study. Drug Deliv. 2018, 25, 78–90. [Google Scholar] [CrossRef] [PubMed]
- Ahmed, T.A.; Alzahrani, M.M.; Sirwi, A.; Alhakamy, N.A. Study the Antifungal and Ocular Permeation of Ketoconazole from Ophthalmic Formulations Containing Trans-Ethosomes Nanoparticles. Pharmaceutics 2021, 13, 151. [Google Scholar] [CrossRef] [PubMed]
- Wagner, J.G. Interpretation of percent dissolved-time plots derived from in vitro testing of conventional tablets and capsules. J. Pharm. Sci. 1969, 58, 1253–1257. [Google Scholar] [CrossRef]
- Higuchi, T. Mechanism of sustained-action medication. Theoretical analysis of rate of release of solid drugs dispersed in solid matrices. J. Pharm. Sci. 1963, 52, 1145–1149. [Google Scholar] [CrossRef]
- Korsmeyer, R.W.; Gurny, R.; Doelker, E.; Buri, P.; Peppas, N.A. Mechanisms of solute release from porous hydrophilic polymers. Int. J. Pharm. 1983, 15, 25–35. [Google Scholar] [CrossRef]
- Peppas, N.A. Analysis of Fickian and non-Fickian drug release from polymers. Pharm. Acta Helv. 1985, 60, 110–111. [Google Scholar]
- Zhu, M.; Wang, J.; Li, N. A novel thermo-sensitive hydrogel-based on poly(N-isopropylacrylamide)/hyaluronic acid of ketoconazole for ophthalmic delivery. Artif. Cells Nanomed. Biotechnol. 2018, 46, 1282–1287. [Google Scholar] [CrossRef]
- Draize, J.H.; Woodard, G.; Calvery, H.O. Methods for the study of irritation and toxicity of substances applied topically to the skin and mucous membranes. J. Pharmacol. Exp. Ther. 1944, 82, 377–390. [Google Scholar]
- Pinna, A.; Donadu, M.G.; Usai, D.; Dore, S.; Boscia, F.; Zanetti, S. In Vitro Antimicrobial Activity of a New Ophthalmic Solution Containing Hexamidine Diisethionate 0.05% (Keratosept). Cornea 2020, 39, 1415–1418. [Google Scholar] [CrossRef]
- Chen, X.; Wu, J.; Sun, L.; Nie, J.; Su, S.; Sun, S. Antifungal Effects and Potential Mechanisms of Benserazide Hydrochloride Alone and in Combination with Fluconazole against Candida albicans. Drug Des. Dev. Ther. 2021, 15, 4701–4711. [Google Scholar] [CrossRef] [PubMed]
- Dethe, M.R.; Prabakaran, A.; Ahmed, H.; Agrawal, M.; Roy, U.; Alexander, A. PCL-PEG copolymer based injectable thermosensitive hydrogels. J. Control. Release 2022, 343, 217–236. [Google Scholar] [CrossRef] [PubMed]
- Vasconcelos, A.; Vega, E.; Pérez, Y.; Gómara, M.J.; García, M.L.; Haro, I. Conjugation of cell-penetrating peptides with poly(Lactic-co-glycolic acid)-polyethylene glycol nanoparticles improves ocular drug delivery. Int. J. Nanomed. 2015, 10, 609–631. [Google Scholar] [CrossRef]
- Ahmed, T.A. Study the pharmacokinetics, pharmacodynamics and hepatoprotective activity of rosuvastatin from drug loaded lyophilized orodispersible tablets containing transfersomes nanoparticles. J. Drug Deliv. Sci. Technol. 2021, 63, 102489. [Google Scholar] [CrossRef]
- Ahmed, T.A.; Al-Abd, A.M. Effect of finasteride particle size reduction on its pharmacokinetic, tissue distribution and cellular permeation. Drug Deliv. 2018, 25, 555–563. [Google Scholar] [CrossRef]
- El-Say, K.M.; El-Helw, A.-R.M.; Ahmed, O.A.; Hosny, K.M.; Ahmed, T.A.; Kharshoum, R.M.; Fahmy, U.A.; Al-Sawahli, M.M. Statistical optimization of controlled release microspheres containing cetirizine hydrochloride as a model for water soluble drugs. Pharm. Dev. Technol. 2015, 20, 738–746. [Google Scholar] [CrossRef]
- Akhtar, N.; Ahmad, M.; Khan, H.M.S.; Akram, J.; Gulfishan; Mahmood, A.; Uzair, M. Formulation and characterization of a multiple emulsion containing 1% L-ascorbic acid. Bull. Chem. Soc. Ethiop. 2010, 24, 1–10. [Google Scholar] [CrossRef]
- Domingues Bianchin, M.; Borowicz, S.M.; da Rosa Monte Machado, G.; Pippi, B.; Stanisçuaski Guterres, S.; Raffin Pohlmann, A.; Meneghello Fuentefria, A.; Clemes Külkamp-Guerreiro, I. Lipid core nanoparticles as a broad strategy to reverse fluconazole resistance in multiple Candida species. Colloids Surfaces B Biointerfaces 2019, 175, 523–529. [Google Scholar] [CrossRef]
- Metwally, S.; Ferraris, S.; Spriano, S.; Krysiak, Z.J.; Kaniuk, Ł.; Marzec, M.M.; Kim, S.K.; Szewczyk, P.K.; Gruszczyński, A.; Wytrwal-Sarna, M.; et al. Surface potential and roughness controlled cell adhesion and collagen formation in electrospun PCL fibers for bone regeneration. Mater. Des. 2020, 194, 108915. [Google Scholar] [CrossRef]
- Rabha, B.; Bharadwaj, K.K.; Baishya, D.; Sarkar, T.; Edinur, H.A.; Pati, S. Synthesis and characterization of diosgenin encapsulated poly-ε-caprolactone-pluronic nanoparticles and its effect on brain cancer cells. Polymers 2021, 13, 1322. [Google Scholar] [CrossRef]
- Zanetti-Ramos, B.G.; Fritzen-Garcia, M.B.; Creczynski-Pasa, T.B.; De Oliveira, C.S.; Pasa, A.A.; Soldi, V.; Borsali, R. Characterization of polymeric particles with electron microscopy, dynamic light scattering, and atomic force microscopy. Part. Sci. Technol. 2010, 28, 472–484. [Google Scholar] [CrossRef]
- Zanetti-Ramos, B.G.; Fritzen-Garcia, M.B.; de Oliveira, C.S.; Pasa, A.A.; Soldi, V.; Borsali, R.; Creczynski-Pasa, T.B. Dynamic light scattering and atomic force microscopy techniques for size determination of polyurethane nanoparticles. Mater. Sci. Eng. C 2009, 29, 638–640. [Google Scholar] [CrossRef]
- Saleh, N.; Elshaer, S.; Girgis, G. Biodegradable Polymers-based Nanoparticles to Enhance the Antifungal Efficacy of Fluconazole against Candida albicans. Curr. Pharm. Biotechnol. 2022, 23, 749–757. [Google Scholar] [CrossRef] [PubMed]
- Brambilla, E.; Locarno, S.; Gallo, S.; Orsini, F.; Pini, C.; Farronato, M.; Thomaz, D.V.; Lenardi, C.; Piazzoni, M.; Tartaglia, G. Poloxamer-Based Hydrogel as Drug Delivery System: How Polymeric Excipients Influence the Chemical-Physical Properties. Polymers 2022, 14, 3624. [Google Scholar] [CrossRef] [PubMed]
- Tkáčová, M.; Živčák, J.; Foffová, P. A Reference for Human Eye Surface Temperature Measurements in Diagnostic Process of Ophthalmologic Diseases. In Proceedings of the Measurement 2011: The 8th International Conference on Measurement, Smolenice, Slovakia, 27–30 April 2011; pp. 406–409. [Google Scholar]
- Ciolacu, D.E.; Nicu, R.; Ciolacu, F. Cellulose-based hydrogels as sustained drug-delivery systems. Materials 2020, 13, 5270. [Google Scholar] [CrossRef]
- Pal, K.; Banthia, A.K.; Majumdar, D.K. Polymeric Hydrogels: Characterization and Biomedical Applications. Des. monomers Polym. 2012, 12, 197–220. [Google Scholar] [CrossRef]
- Suni, E.; Writer, S. How Much Sleep Do We Really Need? Sleep Foundation: Washington, DC, USA, 2022; Available online: https://www.sleepfoundation.org/how-sleep-works/how-much-sleep-do-we-really-need (accessed on 27 December 2022).
- Jaiswal, M.; Kumar, M.; Pathak, K. Zero order delivery of itraconazole via polymeric micelles incorporated in situ ocular gel for the management of fungal keratitis. Colloids Surf. B Biointerfaces 2015, 130, 23–30. [Google Scholar] [CrossRef]
- Lee, C.H.; Li, Y.J.; Huang, C.C.; Lai, J.Y. Poly(ϵ-caprolactone) nanocapsule carriers with sustained drug release: Single dose for long-term glaucoma treatment. Nanoscale 2017, 9, 11754–11764. [Google Scholar] [CrossRef]
- Cao, Y.; Samy, K.E.; Bernards, D.A.; Desai, T.A. Recent advances in intraocular sustained-release drug delivery devices. Drug Discov. Today 2019, 24, 1694–1700. [Google Scholar] [CrossRef]
- Kurniawansyah, I.S.; Rusdiana, T.; Sopyan, I.; Ramoko, H.; Wahab, H.A.; Subarnas, A. In situ ophthalmic gel forming systems of poloxamer 407 and hydroxypropyl methyl cellulose mixtures for sustained ocular delivery of chloramphenicole: Optimization study by factorial design. Heliyon 2020, 6, e05365. [Google Scholar] [CrossRef]
- Soliman, K.A.; Ullah, K.; Shah, A.; Jones, D.S.; Singh, T.R.R. Poloxamer-based in situ gelling thermoresponsive systems for ocular drug delivery applications. Drug Discov. Today 2019, 24, 1575–1586. [Google Scholar] [CrossRef] [PubMed]
- Mansour, M.; Mansour, S.; Mortada, N.D.; Abd ElHady, S.S. Ocular poloxamer-based ciprofloxacin hydrochloride in situ forming gels. Drug Dev. Ind. Pharm. 2008, 34, 744–752. [Google Scholar] [CrossRef] [PubMed]
- Perez, A.P.; Altube, M.J.; Schilrreff, P.; Apezteguia, G.; Celes, F.S.; Zacchino, S.; de Oliveira, C.I.; Romero, E.L.; Morilla, M.J. Topical amphotericin B in ultradeformable liposomes: Formulation, skin penetration study, antifungal and antileishmanial activity in vitro. Colloids Surf. B Biointerfaces 2016, 139, 190–198. [Google Scholar] [CrossRef] [PubMed]
- Liu, Y.; Cui, X.; Zhao, L.; Zhang, W.; Zhu, S.; Ma, J. Chitosan Nanoparticles to Enhance the Inhibitory Effect of Natamycin on Candida albicans. J. Nanomater. 2021, 2021, 6644567. [Google Scholar] [CrossRef]
- U.S. Food and Drug Administration. FDA Drug Safety Communication: FDA Limits Usage of Nizoral (Ketoconazole) Oral Tablets Due to Potentially Fatal Liver Injury and Risk of Drug Interactions and Adrenal Gland Problems; U.S. Food and Drug Administration: Silver Spring, MD, USA, 2013. [Google Scholar]
- Filler, S.G.; Crislip, M.A.; Mayer, C.L.; Edwards, J.E. Comparison of fluconazole and amphotericin B for treatment of disseminated candidiasis and endophthalmitis in rabbits. Antimicrob. Agents Chemother. 1991, 35, 288–292. [Google Scholar] [CrossRef][Green Version]
- Elmotasem, H.; Awad, G.E.A. A stepwise optimization strategy to formulate in situ gelling formulations comprising fluconazole-hydroxypropyl-beta-cyclodextrin complex loaded niosomal vesicles and Eudragit nanoparticles for enhanced antifungal activity and prolonged ocular delivery. Asian J. Pharm. Sci. 2020, 15, 617–636. [Google Scholar] [CrossRef]
- Pathak, M.K.; Chhabra, G.; Pathak, K. Design and development of a novel pH triggered nanoemulsified in-situ ophthalmic gel of fluconazole: Ex-vivo transcorneal permeation, corneal toxicity and irritation testing. Drug Dev. Ind. Pharm. 2013, 39, 780–790. [Google Scholar] [CrossRef]
- Ahmed, T.A. Preparation of finasteride capsules-loaded drug nanoparticles: Formulation, optimization, in vitro, and pharmacokinetic evaluation. Int. J. Nanomed. 2016, 11, 515–527. [Google Scholar] [CrossRef]

| Independent Variables | Low Level (−1) | Medium Level (0) | High Level (+1) | Responses | Units |
|---|---|---|---|---|---|
| PCL in the polymeric matrix, % (X1) | 20 | 40 | 60 | Particle size | nm |
| Addition rate of PCL, mL/min (X2) | 5 | 10 | 15 | Zeta potential | mV |
| Stirring speed, rpm (X3) | 400 | 600 | 800 | Entrapment efficiency | % |
| Formulation Code | Independent Factors | Dependent Factors | ||||
|---|---|---|---|---|---|---|
| X1 | X2 | X3 | Y1 (nm) | Y2 (mV) | Y3 (%) | |
| F1 | 40 | 10 | 600 | 169.4 ± 50.58 | −17.1 ± 5.50 | 99.21 ± 5% |
| F2 | 40 | 15 | 400 | 404.9 ± 50.0 | −23.8 ± 6.35 | 98.64 ± 5% |
| F3 | 20 | 10 | 400 | 147.7 ± 52.20 | −24.7 ± 7.94 | 99.87 ± 5% |
| F4 | 60 | 10 | 800 | 114.3 ± 39.70 | −14.8 ± 7.39 | 99.87 ± 5% |
| F5 | 20 | 5 | 600 | 234.8 ± 122.3 | −22.9 ± 7.79 | 99.9 ± 5% |
| F6 | 60 | 5 | 600 | 280.6 ± 134.7 | −5.67 ± 5.00 | 99.0 ± 5% |
| F7 | 20 | 15 | 600 | 429.3 ± 169.0 | −7.36 ± 4.07 | 99.99 ± 5% |
| F8 | 40 | 10 | 600 | 191.3 ± 61.3 | −17.7 ± 7.00 | 99.0 ± 5% |
| F9 | 40 | 5 | 400 | 228.9 ± 73.18 | −19.0 ± 8.00 | 99.9 ± 5% |
| F10 | 40 | 5 | 800 | 150.4 ± 33.23 | −18.6 ± 6.63 | 99.06 ± 5% |
| F11 | 20 | 10 | 800 | 184.1 ± 62.3 | −16.5 ± 4.84 | 99.06 ± 5% |
| F12 | 40 | 15 | 800 | 179.4 ± 120.1 | −18.8 ± 3.69 | 99.99 ± 5% |
| F13 | 60 | 10 | 400 | 441.8 ± 181.4 | −17.4 ± 4.41 | 95.0 ± 6% |
| F14 | 60 | 15 | 600 | 325.7 ± 159.5 | −11.5 ± 5.58 | 95.0 ± 6% |
| F15 | 40 | 10 | 600 | 160.3 ± 35.02 | −16.2 ± 7.24 | 99.87 ± 5% |
| Factors | Particle Size (Y1), nm | Zeta Potential (Y2), mV | Entrapment Efficiency (Y3), % | ||||||
|---|---|---|---|---|---|---|---|---|---|
| Estimate | F-Ratio | p-Value | Estimate | F-Ratio | p-Value | Estimate | F-Ratio | p-Value | |
| X1 | 48.25 | 2.54 | 0.1718 | −5.523 | 8.99 | 0.0302 * | −2.488 | 15.44 | 0.0111 * |
| X2 | 117.775 | 15.14 | 0.0115 * | −1.178 | 0.41 | 0.5508 | −1.061 | 2.81 | 0.1547 |
| X3 | −148.775 | 24.16 | 0.0044 * | −4.05 | 4.83 | 0.0792 | 1.144 | 3.26 | 0.1306 |
| X1X1 | 131.533 | 8.72 | 0.0318 * | −6.853 | 6.39 | 0.0527 | −1.835 | 3.87 | 0.1061 |
| X1X2 | −61.65 | 2.07 | 0.2094 | 10.685 | 16.82 | 0.0093 * | −2.045 | 5.22 | 0.0712 |
| X1X3 | −181.95 | 18.07 | 0.0081 * | 2.8 | 1.16 | 0.3316 | 2.844 | 10.08 | 0.0247 * |
| X2X2 | 169.383 | 14.45 | 0.0126 * | −3.453 | 1.62 | 0.2589 | 0.056 | 0.00 | 0.9548 |
| X2X3 | −73.5 | 2.95 | 0.1466 | −2.3 | 0.78 | 0.4177 | 1.094 | 1.49 | 0.2764 |
| X3X3 | −34.917 | 0.61 | 0.4687 | 9.533 | 12.36 | 0.0170* | 0.017 | 0.00 | 0.9862 |
| R2 | 94.63 | 91.67 | 89.42 | ||||||
| Adj-R2 | 84.97 | 76.69 | 70.37 | ||||||
| Independent Variables | Optimum | Dependent Variables | Predicted Values | Observed Values | Residuals |
|---|---|---|---|---|---|
| PCL in polymeric matrix, % (X1) | 20 | Particle size (nm) | 134.05 | 145.5 | 11.45 |
| Addition rate of PCL, mL/min (X2) | 6.27 | Zeta potential (mV) | −27.14 | −29.23 | 2.09 |
| Stirring speed, rpm (X3) | 400 | Entrapment efficiency (%) | 100.6 | 98.2 | −2.4 |
Disclaimer/Publisher’s Note: The statements, opinions and data contained in all publications are solely those of the individual author(s) and contributor(s) and not of MDPI and/or the editor(s). MDPI and/or the editor(s) disclaim responsibility for any injury to people or property resulting from any ideas, methods, instructions or products referred to in the content. |
© 2022 by the authors. Licensee MDPI, Basel, Switzerland. This article is an open access article distributed under the terms and conditions of the Creative Commons Attribution (CC BY) license (https://creativecommons.org/licenses/by/4.0/).
Share and Cite
Almehmady, A.M.; El-Say, K.M.; Mubarak, M.A.; Alghamdi, H.A.; Somali, N.A.; Sirwi, A.; Algarni, R.; Ahmed, T.A. Enhancing the Antifungal Activity and Ophthalmic Transport of Fluconazole from PEGylated Polycaprolactone Loaded Nanoparticles. Polymers 2023, 15, 209. https://doi.org/10.3390/polym15010209
Almehmady AM, El-Say KM, Mubarak MA, Alghamdi HA, Somali NA, Sirwi A, Algarni R, Ahmed TA. Enhancing the Antifungal Activity and Ophthalmic Transport of Fluconazole from PEGylated Polycaprolactone Loaded Nanoparticles. Polymers. 2023; 15(1):209. https://doi.org/10.3390/polym15010209
Chicago/Turabian StyleAlmehmady, Alshaimaa M., Khalid M. El-Say, Manal A. Mubarak, Haneen A. Alghamdi, Njood A. Somali, Alaa Sirwi, Rahmah Algarni, and Tarek A. Ahmed. 2023. "Enhancing the Antifungal Activity and Ophthalmic Transport of Fluconazole from PEGylated Polycaprolactone Loaded Nanoparticles" Polymers 15, no. 1: 209. https://doi.org/10.3390/polym15010209
APA StyleAlmehmady, A. M., El-Say, K. M., Mubarak, M. A., Alghamdi, H. A., Somali, N. A., Sirwi, A., Algarni, R., & Ahmed, T. A. (2023). Enhancing the Antifungal Activity and Ophthalmic Transport of Fluconazole from PEGylated Polycaprolactone Loaded Nanoparticles. Polymers, 15(1), 209. https://doi.org/10.3390/polym15010209

